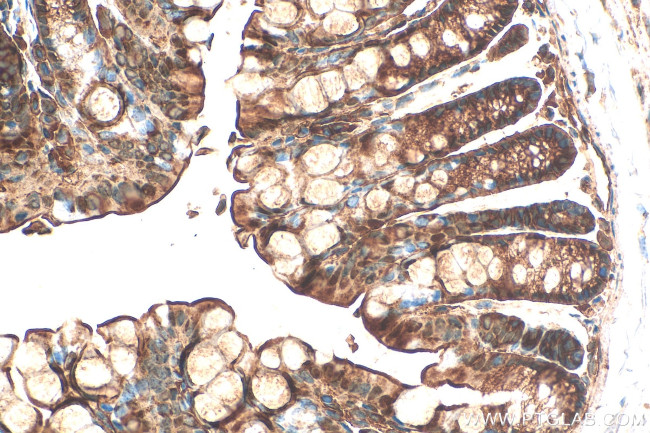
SULT1B1 Antibody in Immunohistochemistry (Paraffin) (IHC (P))

Search
Proteintech
SULT1B1 Recombinant Rabbit Monoclonal Antibody (240119C12)
{{$productOrderCtrl.translations['antibody.pdp.commerceCard.promotion.promotions']}}
{{$productOrderCtrl.translations['antibody.pdp.commerceCard.promotion.viewpromo']}}
{{$productOrderCtrl.translations['antibody.pdp.commerceCard.promotion.promocode']}}: {{promo.promoCode}} {{promo.promoTitle}} {{promo.promoDescription}}. {{$productOrderCtrl.translations['antibody.pdp.commerceCard.promotion.learnmore']}}
产品信息
83228-1-RR
种属反应
宿主/亚型
Expression System
分类
类型
克隆号
抗原
偶联物
形式
浓度
规格
纯化类型
保存液
内含物
保存条件
运输条件
产品详细信息
Immunogen sequence: MLSPKDILRK DLKLVHGYPM TCAFASNWEK IEQFHSRPDD IVIATYPKSG TTWVSEIIDM ILNDGDIEKC KRGFITEKVP MLEMTLPGLR TSGIEQLEKN PSPRIVKTHL PTDLLPKSFW ENNCKMIYLA RNAKDVSVSY YHFDLMNNLQ PFPGTWEEYL EKFLTGKVAY GSWFTHVKNW WKRKEEHPIL FLYYEDMKEN PKEEIKKIIR FLEKNLNDEI LDRIIHHTSF EVMKDNPLVN YTHLPTTVMD HSKSPFMRKG TAGDWKNYFT VAQNEKFDAI YETEMSKTAL QFRTEI
靶标信息
Sulfotransferase enzymes catalyze the sulfate conjugation of many hormones, neurotransmitters, drugs, and xenobiotic compounds. These cytosolic enzymes are different in their tissue distributions and substrate specificities. The gene structure is similar among family members. However, the total genomic length of this gene is greater than that of other SULT1 genes.
仅用于科研。不用于诊断过程。未经明确授权不得转售。
篇参考文献 (0)
生物信息学
蛋白别名: cytosolic sulfotransferase; DOPA/tyrosine sulfotransferase; ST1B1; Sulfotransferase 1B1; Sulfotransferase 1B2; Sulfotransferase family cytosolic 1B member 1; sulfotransferase family, cytosolic, 1B, member 1; Thyroid hormone sulfotransferase
基因别名: ST1B1; ST1B2; St2b2; SULT1B1; SULT1B2
UniProt ID: (Human) O43704, (Mouse) Q9QWG7
Entrez Gene ID: (Human) 27284, (Mouse) 56362